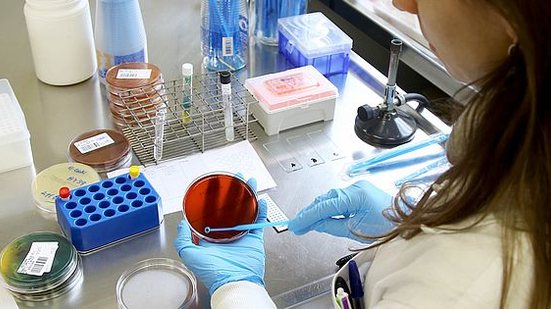
Foto: Divulgação Lacen Paraná

Ação Civil Pública proposta pela Aduseps solicitou a inclusão, na cobertura mínima obrigatória, dos testes - que especificam quem já foi ou não infectado pelo Coronavírus, além dos já curados ou com a doença ativa
A Justiça Federal acaba de obrigar a Agência Nacional de Saúde Suplementar (ANS) a incluir, no rol de cobertura obrigatória dos planos de saúde, a realização dos exames sorológicos de IGM e IGG para o Covid-19, mediante requisição médica – seja ela física ou eletrônica. A liminar, concedida ontem (10), na 6ª Vara Federal de Pernambuco, deu-se em resposta a uma Ação Civil Pública proposta, na última segunda-feira (08), pela Associação de Defesa dos Usuários de Seguros, Planos e Sistemas de Saúde (Aduseps).
LEIA TAMBÉM
A entidade ingressou com o pedido em razão da necessidade de as operadoras cobrirem, para os seus beneficiários, diagnósticos mais precisos acerca do Coronavírus. É que, até então, a ANS apenas incluíra – por meio da Resolução Normativa n° 453, editada em março deste ano – a pesquisa por RT-PCR, que apenas detecta a contaminação (ou não) pelo vírus no ato da coleta. “Trata-se de um teste que não garante se o paciente já teve o vírus ou não. Como o Brasil vai reabrir as portas se não sabe quem está infectado, quem já teve a doença e quem está suscetível?”, questiona Renê Patriota, coordenadora executiva da Aduseps.
Mais precisos, os exames de IGM e IGG, por sua vez, informam se o paciente ainda não foi infectado, se contraiu e foi curado ou se apresenta quadro ativo da doença. “Os pacientes com a doença ativa aguda irão apresentar o IGM positivo e o IGG negativo, enquanto que os outrora infectados e já curados irão testar o oposto: IGM negativo e IGG positivo. Já com os ainda não infectados, ambos serão negativos”, explica Renê.
A decisão, assinada pelo juiz Hélio Silvio Ourém Campos, validou o argumento da Aduseps de que, com a permissão da abertura gradual das atividades cotidianas, faz-se necessária a identificação tanto dos cidadãos já infectados e curados – ou seja, os considerados fora de risco de infecção aguda – quanto dos que se encontram na fase aguda da doença, com alto risco de contaminar outras pessoas. “Essa identificação é essencial para que a vida continue”, pontua Renê.
A médica e advogada lembra, ainda, a atual fase crítica em que se encontra o Brasil, quando figura entre os países com maior número de mortes diárias pelo Coronavírus e, em contrapartida, é um dos que menos realizam testes. “Os consumidores, que já pagam seu pelo plano de saúde, ainda tinham que arcar com o valor dos exames, por fora. Foi preciso, por meio dessa importante decisão, que a Justiça obrigasse a ANS a cumprir aquilo que ela deveria ter feito de forma proativa: mandar as operadoras cobrirem os diagnósticos. Os consumidores, agora, já têm esse direito”, comemora Renê.
LEIA MAIS
+Lidas